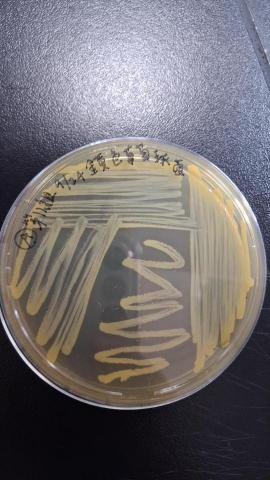
YA-YI - 菌落

返回
分享

YA-YI - 聖經導讀
0.0
(0)
0次僱用
通過身分認證
台中市霧峰區
照片/影片(4)
專家介紹
服務項目
| 服務方式 | 線上服務 |
| 學生經驗 | 沒有閱讀聖經經驗、曾初步閱讀聖經、曾深度研讀聖經、其他 |
| 類別 | 舊約聖經、新約聖經、其他 |
| 課程形式 | 私人課程、團體課程、其他 |
| 上課頻率 | 每週一次、每週兩次、每兩週一次、其他 |
服務時段
星期一
09:00 - 21:00
星期二
14:00 - 21:00
星期三
休息
星期四
19:00 - 21:00
星期五
17:00 - 21:00
星期六
09:00 - 21:00
星期日
休息
聖經導讀相關評價
常見問題
1.自我介紹
2.專業背景
3.服務方式
4.收費方式
5.來往客戶
聖經導讀
洽談後報價